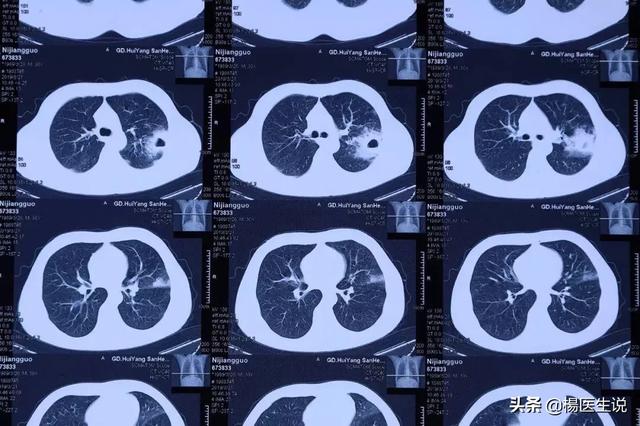

Quelle est la substance contenue dans les mucosités expectorées par les poumons ? S'agit-il d'une toxine présente dans l'organisme ?
Quelle est la substance contenue dans les mucosités expectorées par les poumons ? S'agit-il d'une toxine présente dans l'organisme ?
Souvent, dans la vie, on observe des symptômes de toux de mucosités. En fait, beaucoup de gens se demandent d'où viennent les mucosités, car les mucosités sont expectorées des poumons et contiennent quelles substances ? Les mucosités proviennent-elles des toxines de l'organisme ? Aujourd'hui, nous vous donnons un peu de science.
La toux est un réflexe physiologique d'autoprotection qui permet d'expulser les sécrétions ou les corps étrangers des voies respiratoires. Une toux appropriée est donc très bénéfique pour le corps humain. En revanche, une toux violente trop fréquente affecte le travail et la vie normale et n'est pas bénéfique pour le corps humain.

Le système respiratoire du corps humain se compose des voies nasales, du pharynx, de la trachée, des bronches et des alvéoles. La paroi interne de la trachée et des bronches est recouverte d'une couche de muqueuse, et dans la couche inférieure de la muqueuse se trouvent de nombreuses glandes muqueuses et glandes plasmatiques. Normalement, ces glandes sécrètent une petite quantité de mucus pour recouvrir les parois des voies respiratoires. Ce mucus protège les parois des voies respiratoires et sert à les hydrater dans une certaine mesure, tout en adhérant aux substances nocives. Lorsque les voies respiratoires sont envahies par des substances nocives, telles que le pollen, la fumée de pétrole, les acariens et même des agents pathogènes comme les virus, les bactéries, les mycoplasmes, les chlamydiae, les rickettsies, etc., la sécrétion des glandes trachéales est hypersécrétoire par réflexe et une grande quantité de mucus est sécrétée. l'environnement écologique normal des poumons.

Si ces substances nocives et ces agents pathogènes provoquent des infections des poumons, des bronches, etc., et qu'une grande quantité de sécrétions inflammatoires est exsudée, les expectorations deviennent de plus en plus abondantes. Elles contiennent non seulement du mucus sécrété par les glandes, mais aussi des agents pathogènes et des substances nocives, vivants ou morts, ainsi qu'une grande quantité de sécrétions inflammatoires dues à la réponse immunitaire, et également des fragments de tissus détachés. À ce moment-là, il s'agit d'un état pathologique, la toux peut être plus sévère, l'expectoration plus abondante et plus épaisse.

Les toxines désignent donc ces substances nocives ainsi que les agents pathogènes et la grande quantité de sécrétions inflammatoires produites par la réaction inflammatoire. L'élimination de ces toxines sous forme de mucosités par une toux constante constitue en effet une protection pour l'organisme.

Cependant, lorsque les expectorations deviennent de plus en plus épaisses, voire de couleur jaune ou verte, ou même accompagnées de sang, la réaction inflammatoire est plus grave et une intervention médicale s'impose.
Dans la pratique clinique, le caractère et la couleur des expectorations permettent de porter un jugement préliminaire sur l'état de santé : par exemple, si les expectorations sont jaunes, vertes et épaisses, cela indique une infection bactérienne purulente dans les poumons, qui est fréquente dans la pneumonie, la bronchite, etc. Si les expectorations sont de couleur rouille, cela suggère une pneumonie lobaire causée par une infection streptococcique hémolytique. Si les expectorations sont de couleur chocolat, il s'agit d'une pneumonie due à une infection par des amibes. Si les expectorations sont de couleur brune et qu'elles contiennent des caillots de sang, il faut envisager une crise aiguë de cardiopathie pulmonaire chronique. Si les expectorations sont grises ou noires pendant une longue période, il faut envisager une pneumoconiose. Si les expectorations sont roses et mousseuses, il faut envisager un œdème pulmonaire causé par une insuffisance cardiaque gauche. Si les expectorations sont souvent rouge vif, il faut envisager une tuberculose, un infarctus pulmonaire, voire un cancer broncho-pulmonaire.

Il est recommandé aux personnes qui toussent des mucosités de veiller à se réchauffer, d'éviter le froid et, dans les endroits bondés, de porter des masques chirurgicaux, d'éviter autant que possible d'aller dans un environnement où l'air est sale, et de veiller à ce que la ventilation intérieure garantisse un air frais, et si les symptômes mentionnés ci-dessus sont évidents, vous devriez consulter un médecin en temps utile, afin d'obtenir un diagnostic clair et un traitement rapide de la cause de la maladie. Pendant la période de rémission de la maladie, vous pouvez également faire de l'exercice et du fitness, comme le jogging, la natation, le tai-chi, etc. pour améliorer la condition physique et la fonction cardio-pulmonaire, et vous faire injecter régulièrement le vaccin contre la grippe et la pneumonie.
Il y a quelque temps, dans un square pour prendre le frais, j'ai entendu à côté de quelques vieux hommes discuter, l'un d'eux semble être assez "savant", à l'autre plusieurs personnes pour enseigner "le froid de l'estomac naît du flegme, la déficience des reins naît du flegme, la chaleur du foie naît du flegme ......". La chose XX pour faire du thé pour boire le flegme est très bonne ...". Je ne sais pas trop de quoi je parle, mais je ne sais pas trop de quoi je parle", a-t-il dit !
Qu'est-ce que le flegme ? S'agit-il vraiment d'une toxine ? Qu'est-ce que l'expectoration d'après la définition de la toux ?
La toux est un réflexe défensif qui permet de dégager les voies respiratoires.Sécrétions respiratoires及corps étranger dans les voies respiratoires。
Comme vous pouvez le constater, il n'existe pas de toux flatulente ; la toux suppose la présence de deux facteurs déclenchants : les sécrétions respiratoires et les corps étrangers dans les voies respiratoires.

Les sécrétions respiratoires et les corps étrangers présents dans les voies respiratoires nous indiquent à leur tour la nature des mucosités !
I. Réfléchissez à la question suivante : les voies respiratoires sont-elles sèches ?
En effet, nos voies respiratoires ne sont pas sèches, mais plutôt humides.
Pensez-y, nos nez et nos gorges, en automne et en hiver ou avec moins d'eau, ne sont pas difficiles à cause de la sécheresse.
Les voies respiratoires sont humides parce que les glandes et les cellules de la muqueuse bronchique sécrètent une petite quantité de mucus. Dans des circonstances normales, la quantité de ce mucus est faible et ne sert qu'à l'hydratation.
II. l'origine des mucosités
Lorsqu'une inflammation se produit dans les voies respiratoires, il y a une augmentation de la sécrétion du mucus susmentionné, une augmentation de la perméabilité des parois capillaires et une exsudation de plasma. À ce stade, l'exsudat contenant des érythrocytes, des leucocytes, des macrophages, de la fibrine, etc., se mélange au mucus, aux poussières inhalées et à certaines substances destructrices des tissus pour former des mucosités.

L'expectoration est un phénomène pathologique plus ou moins grave. Il est interdit de cracher, comme dans le cas de la tuberculose, où Mycobacterium tuberculosis peut être trouvé dans les expectorations, et dans d'autres infections respiratoires et parasites pulmonaires, où des agents pathogènes peuvent être détectés dans les expectorations.
III. quel type de mucosités y a-t-il ?
Les expectorations sont classées en mucus, plasma, pus et sang.
Les expectorations mucoïdes sont fréquentes aux premiers stades de la bronchite aiguë, de l'asthme bronchique et de la pneumonie ;
Les expectorations plasmatiques sont fréquentes en cas d'œdème pulmonaire ;
Les expectorations purulentes sont souvent associées à des infections bactériennes purulentes des voies respiratoires inférieures ;
Les expectorations sanglantes sont dues à une agression des muqueuses des voies respiratoires, à une atteinte des capillaires ou à une infiltration de sang dans les alvéoles. Ainsi, des expectorations de natures diverses peuvent apparaître teintées de sang.
IV. couleur des expectorations
Des expectorations de couleur différente peuvent indiquer des infections à germes différents.
Les crachats de couleur rouille sont typiques de la pneumonie à pneumocoques ;
Crachats jaune-vert ou vert émeraude, souvent infection à Pseudomonas aeruginosa ;
Les expectorations blanches et épaisses, qui peuvent être tirées en filaments, sont souvent le signe d'une infection fongique ;
Des expectorations roses et mousseuses sont caractéristiques d'un œdème pulmonaire et suggèrent un état critique.
......
Qui est sujet à la production de mucosités, qui produit rapidement des mucosités en cas d'hémorragie cérébrale, qui est alité et a des difficultés à éliminer les mucosités ?
I. Hémorragie cérébrale
L'hémorragie cérébrale survient généralement de manière soudaine et le flegme est l'une des complications les plus courantes de l'hémorragie cérébrale qui survient peu de temps après le début de la maladie. Les mucosités sont parfois présentes tout au long de l'hémorragie cérébrale ou pendant un certain temps après la guérison, et peuvent mettre la vie en danger dans les cas les plus graves.
Dans ce groupe de patients, les expectorations sont dues à une pneumonie, dont les facteurs de causalité les plus courants sont les suivantsDysphagie et aspiration des vomissures.

L'étouffement, fréquent chez les victimes d'accidents vasculaires cérébraux, est dû aux raisons mentionnées ci-dessus.
L'œsophage et la trachée sont reliés sous la bouche, c'est-à-dire qu'il y a une bifurcation sous la bouche avec l'œsophage d'un côté et la trachée de l'autre.
Lors de la déglutition, la trachée est temporairement fermée pour empêcher la nourriture et la salive d'y pénétrer. Lorsque de la salive ou des aliments pénètrent dans la trachée pour une raison quelconque, une toux violente se produit comme mécanisme de protection, et la toux rejette ces corps étrangers qui sont tombés par erreur dans la trachée.
Cependant, les patients souffrant d'hémorragie cérébrale ou d'infarctus cérébral sont parfois incapables d'achever le mouvement de déglutition ou le mouvement de déglutition est lent, ce qui entraîne l'entrée d'aliments dans les voies respiratoires, et si le réflexe de toux est également altéré ou si la toux est faible, le mécanisme de protection échoue et une pneumonie d'aspiration se produit.
Deuxièmement, les personnes alitées ont beaucoup de mucosités et il est difficile de s'en débarrasser
Si vous êtes alité pendant une longue période pour une raison quelconque, les mucosités sont le problème le plus important et le point central des soins quotidiens.
Le problème à l'origine de cet aspect est très lié à ce terme médical : la pneumonie fulgurante.

Causes de la formation de la pneumonie crurale :
Certaines maladies entraînent une diminution de la résistance et un affaiblissement des mouvements respiratoires, couplés à un alitement prolongé entraînant une congestion, une stase et un œdème prolongés à la base des poumons, ce qui est propice à la croissance et à la reproduction des bactéries.
Pour s'attaquer aux causes de la formation, la prévention est la suivante :
①, essayez de l'aider à se retourner et encouragez les exercices de respiration profonde et ample, tout en vous abstenant de fumer.
②, essayez de prendre une position assise, tapotez souvent le dos pour faciliter l'évacuation des mucosités.
(iii) Pour ceux qui peuvent se lever, essayez de les aider à se lever.
④. Si la maladie primaire provoque des douleurs nécessitant des analgésiques, ceux-ci doivent être pris à petites doses, car la plupart des analgésiques ont pour effet secondaire d'inhiber la respiration.
⑤. Si les expectorations sont épaisses et difficiles à expectorer, la nébulisation peut être utilisée pour diluer les expectorations et les évacuer.
(vi) Il est conseillé aux personnes présentant du pus et des expectorations de consulter un médecin.
Cracher des mucosités est probablement un problème auquel nous sommes tous confrontés un jour ou l'autre. Cette sensation d'être coincé dans la gorge est la seule façon de l'expectorer.
D'où et comment proviennent les mucosités que vous crachez habituellement ?
Les parois internes de la trachée et des bronches sont recouvertes d'une membrane muqueuse composée d'épithélium cylindrique cilié et de cellules à cupules, et contiennent davantage de glandes muqueuses et de glandes plasmatiques dans la couche sous-muqueuse. Dans des circonstances normales, les cellules à cupules et les glandes sécrètent une petite quantité de mucus, couvrant la surface de la couche de la membrane muqueuse, utilisée pour capturer les particules de poussière, les bactéries et autres débris inhalés, puis avec l'aide de l'épithélium cylindrique cilié des cils se balancent, à leur tour, ils seront évacués vers la trachée, le larynx, et enfin à travers la cavité buccale, c'est à dire, l'expectoration.

Lorsque la trachée, les bronches et les poumons sont stimulés par des facteurs nocifs, ce qui entraîne une congestion et un œdème de la muqueuse respiratoire, puis une infiltration d'un grand nombre de cellules inflammatoires, une vasodilatation, une exsudation accrue, une hyperplasie et une hypertrophie des cuprocytes et des glandes, ainsi qu'une forte sécrétion de mucus, et en même temps, sous l'action des bactéries et de leurs toxines, une certaine dégénérescence et une nécrose des cellules tissulaires sont produites, qui sont retenues dans les bronches et constituent, avec le mucus, l'expectoration.
En tant que sécrétion de l'organisme, les mucosités reflètent directement l'état du système respiratoire. Des mucosités de couleurs différentes indiquent des problèmes différents.
1. expectoration blanche :Si les mucosités expectorées sont claires ou blanches, il peut s'agir d'une irritation causée par la pollution de l'air ou d'une infection virale telle qu'un rhume ou une bronchite bénigne. Des mucosités blanches signifient souvent que l'irritation est légère et sans gravité. Les personnes en bonne santé crachent parfois de petites quantités de mucosités blanches.
2. expectoration jaune ou expectoration de pus vert :Si les expectorations sont épaisses, volumineuses, jaunes ou verdâtres, cela indique que l'organisme a été infecté, le plus souvent par des bactéries purulentes telles que les staphylocoques, les streptocoques et les Pseudomonas aeruginosa.

3. mucosités rouges :Si vous crachez des expectorations rouges, cela signifie qu'il y a du sang dans les expectorations. On l'observe le plus souvent dans la tuberculose, les tumeurs pulmonaires, la dilatation des bronches et d'autres maladies. Bien entendu, il convient avant tout d'exclure tout traumatisme buccal. Une toux forte peut également provoquer une rupture microvasculaire de la gorge et entraîner une hémorragie, mais cette situation n'est pas grave. Mais pour plus de sécurité, il ne faut pas prendre à la légère les expectorations rouges, il faut se rendre à l'hôpital à temps pour en déterminer la cause et suivre un traitement actif.
4. expectoration rose et mousseuse :Si des expectorations roses et bulleuses sont expectorées, il convient d'évoquer la possibilité d'un œdème pulmonaire. Le patient peut être en détresse respiratoire et avoir l'impression de se noyer. Il est important de ne pas attendre et d'emmener immédiatement le patient à l'hôpital.
5. expectoration gélatineuse de couleur rouille :Si les expectorations expectorées sont de couleur rouge-brun, rouille ou café et gélatineuses, il peut s'agir d'une pneumonie causée par un pneumocoque. Les patients peuvent ressentir des douleurs thoraciques et de la fièvre.

6. expectorations grises ou noires :Si des expectorations grises ou noires sont crachées, elles sont généralement dues à de la limaille de fer, de la poussière de charbon de bois ou des dépôts de poussière. Ce phénomène est fréquent chez les patients souffrant de maladies professionnelles, telles que la silicose ou le poumon fibrotique des travailleurs du textile.
★ Si cette réponse est utile, merci de l'aimer et de la soutenir !
Je me souviens que mon professeur m'a raconté qu'à l'époque où la technologie des tests n'était pas encore très avancée, il y avait un médecin qui essayait personnellement la saveur des mucosités d'un patient afin de diagnostiquer une maladie. Par coïncidence, dans le cas de certains patients sans ventilateur, les mucosités présentes dans la gorge risquaient d'entraîner la suffocation du patient, mais il y a aussi des cas où le médecin a directement aidé le patient à aspirer les mucosités avec sa bouche, quelle que soit la situation. Les médecins sont formidables, mais la plupart de ces scènes sont seulement entendues et non vues de leurs propres yeux. Il y a peu de temps, une vidéo très chaude a été diffusée : une mère de son enfant, en raison d'un rhume, respire mal, l'enfant est très petit et ne se mouche pas ; la mère utilise aussi directement la bouche pour aider le bébé à aspirer la morve. De toute façon, quel genre de substance sont les mucosités ? S'agit-il vraiment d'une toxine dans l'organisme ? Aujourd'hui, nous allons vous parler.

痰
L'essence du flegme est une sécrétion qui protège les voies respiratoires et les poumons, sans laquelle nos voies respiratoires s'assècheront et nous éprouverons de l'inconfort. En fait, le flegme est souvent présent dans le corps, même en bonne santé. En général, il s'écoule vers l'estomac sans que l'on s'en rende compte, car la sécrétion est faible. Cependant, lorsque des corps étrangers tels que des virus et des bactéries pénètrent dans l'organisme, ils s'y enchevêtrent et, lorsque les muqueuses des voies respiratoires sont irritées, les mucosités, qui deviennent collantes et colorées, sont expectorées par la toux.

De minuscules "cils" à la surface des cellules épithéliales de la muqueuse de l'appareil respiratoire se déplacent des voies aériennes inférieures vers les voies aériennes supérieures afin de repousser le corps étranger vers l'extérieur. C'est une défense écologique humaine que de recracher les corps étrangers mélangés aux mucosités. En fait, de nombreux organes de notre corps ont cette fonction de rejet des accidents, le plus direct étant l'éternuement, si des corps étrangers pénètrent dans notre cavité nasale, nous les expulserons hors du corps par le biais du flux d'air à grande vitesse. Et s'il s'agit de quelque chose de nocif pour le corps, s'il envahit notre peau, le corps va également par la voie de l'inflammation, l'écoulement constant vers l'extérieur d'un certain liquide, ces choses appartenant à notre corps, il y a une rupture dans la peau pour le laisser s'écouler de la même manière.
Signification des différentes couleurs de l'expectoration
Crachats clairs blancs ou incoloresIl ne s'agit généralement pas d'une infection bactérienne, mais d'une infection virale telle que l'asthme. Si les mucosités sont collantes, il est plus probable qu'il s'agisse d'asthme.
Un peu de mucosités jaunes.La plupart des expectorations froides prennent une couleur légèrement jaune. Cela est dû à un mélange de globules blancs et de débris provenant de la lutte contre les bactéries et autres. Ce phénomène reste relativement courant et ne se produit généralement pas au début d'un rhume. Il survient environ trois à cinq jours après un rhume et devient de plus en plus jaune.
mucosités vertesComme la couleur jaune, elle est dans la plupart des cas la cause d'une infection bactérienne. Mais l'expectoration verte est plus souvent considérée comme un symptôme de bronchite chronique, de bacille de la grippe et de cisterna magna.
Bien sûr, certaines personnes peuvent avoir du sang mélangé à leurs expectorations, et une grande partie des personnes peuvent avoir du sang dans leurs expectorations en raison d'une toux excessive, ce qui n'est généralement pas un gros problème, mais pour plus de sécurité, il est préférable de se rendre à l'hôpital pour un examen spécifique.

En cas de toux de mucosités, de nombreuses personnes ont l'impression que les mucosités sont coincées dans la gorge et qu'elles ne peuvent pas être crachées et avalées, ce qui est vraiment difficile à supporter. La raison possible est que les mucosités sont trop épaisses et collantes, il faut donc boire beaucoup d'eau pour les diluer. Bien sûr, boire plus d'eau n'est pas toujours efficace, vous pouvez essayer le traitement par nébulisation, un liquide médicinal peut aider à diluer les mucosités immédiatement et vous aider à les expectorer. Bien entendu, vous risquez de voir votre toux s'aggraver par la suite, car ce traitement peut irriter les voies respiratoires et a également pour but d'aider à l'expectoration des mucosités.
résumés
Les mucosités sont des sécrétions normales de notre corps. Lorsque le corps est envahi par des virus, ces mucosités collantes les enveloppent et les expulsent par certains tissus du corps. En raison des différentes substances enveloppées, les mucosités changent non seulement de couleur, mais deviennent également collantes et, dans certains cas, elles dégagent même une mauvaise odeur. Bien que la façon dont ces mucosités sont expulsées puisse sembler dégoûtante, il s'agit également d'un mécanisme d'autoprotection de notre corps. Par conséquent, les mucosités en elles-mêmes ne sont pas "toxiques", mais lorsqu'elles sont enveloppées de substances supplémentaires, elles deviennent "toxiques".
Merci d'avoir lu, j'espère que ma réponse pourra vous aider, si vous pensez que ce n'est pas mal, donnez moi un like pour m'encourager, si vous pouvez aussi me faire part de vos inquiétudes, je pense que c'est le plus grand soutien pour moi, merci ?
Allez, où sont toutes les toxines ? Le plus grand organe de détoxification du corps s'appelle le foie et le plus grand organe de détoxification s'appelle les reins. En outre, la transpiration n'est pas une détoxification, la toux n'est pas une détoxification et la défécation n'est pas une détoxification !
Qu'est-ce que le "flegme" ?
En fait, dans notre état normal, les voies respiratoires sécrètent en permanence du "mucus". Cette fine couche de mucus peut humidifier l'air dans les poumons, adsorber la poussière, les particules, contenir ses propres cellules immunitaires, mais aussi tuer une variété de micro-organismes en suspension dans l'air. Cependant, la quantité de ce "mucus" est généralement faible et il est avalé lorsque nous nous raclons la gorge. Cependant, lorsqu'une inflammation se produit dans les voies respiratoires, elle stimule la sécrétion de mucus. D'une part, davantage de cellules immunitaires sont mobilisées pour tuer l'ennemi et, d'autre part, le mécanisme d'autoprotection de la "toux" est activé pour expulser les corps étrangers recouverts de mucus, les micro-organismes pathogènes, les cellules inflammatoires mobilisées et les membranes muqueuses détachées des voies respiratoires par la toux, ce qui aboutit à la formation de "mucosités". Les "mucosités" se forment. Par conséquent, la fonction principale du "flegme" est de se défendre contre les agressions extérieures et n'a rien à voir avec l'élimination des toxines.

Quand crachez-vous des mucosités ?
1. inflammation chronique des voies respiratoiresDes expectorations blanches et collantes peuvent être crachées si le tabagisme est suivi d'un autre tabagisme, ou si vous souffrez déjà de maladies pulmonaires chroniques telles que la bronchite chronique ou la pharyngite. L'emploi à long terme dans les mines de charbon, le charbon de bois et d'autres professions connexes peut entraîner une coloration noire des expectorations.
2. les infections respiratoires :Les infections des voies respiratoires supérieures, généralement causées par des virus, donnent généralement lieu à des "expectorations blanches". Les infections des voies respiratoires inférieures, généralement causées par des bactéries, sont légèrement plus colorées. Pour Streptococcus pneumoniae, les expectorations sont généralement de couleur rouille ; pour Pseudomonas aeruginosa, les expectorations sont vertes ; pour Staphylococcus aureus, les expectorations sont généralement épaisses et jaunes ; et pour les expectorations rouge brique, ressemblant à de la gelée, il peut s'agir de Klebsiella pneumoniae.

3. l'insuffisance cardiaque :Une mauvaise fonction cardiaque, en particulier chez les patients souffrant d'insuffisance cardiaque gauche, peut entraîner une stase pulmonaire. L'augmentation de la pression dans les vaisseaux sanguins pulmonaires entraîne une fuite de liquide vers l'extérieur des vaisseaux sanguins, ce qui stimule le réflexe de toux et la formation d'expectorations. Ces expectorations sont typiquement "roses et mousseuses". Il est important de noter que le traitement de ces patients se concentre sur l'amélioration de la fonction cardiaque plutôt que sur les "mucosités".

4. les tumeurs pulmonaires :Bien que de nombreux patients atteints d'un cancer du poumon se plaignent de la présence de sang dans leurs expectorations, la tumeur pulmonaire n'est en fait pas à l'origine de la formation des expectorations. Lorsque le patient crache des expectorations en raison d'un tabagisme prolongé ou d'une maladie pulmonaire, la tumeur envahit les petits vaisseaux sanguins des poumons et les rompt, se mélangeant aux expectorations et provoquant des "expectorations sanglantes".

Je suis le Dr Yang, cardiologue dans un hôpital tertiaire de Pékin. N'hésitez pas à me suivre et à me laisser un message, je ferai de mon mieux pour répondre à vos questions !
Le flegme est un mélange anormal et nocif des voies respiratoires formé par les sécrétions respiratoires (fluides), les fuites, les exsudats (inflammatoires, cancéreux et traumatiques), les cellules de l'épithélium respiratoire, les micro-organismes pathogènes tels que les bactéries et les virus qui pénètrent dans les voies respiratoires, et les substances nocives produites par leur réponse inflammatoire dans les voies respiratoires.
Il en résulte queLes mucosités sont des substances nocives qui se forment dans les voies respiratoires, ce qui n'exclut évidemment pas la présence de toxines dans l'organisme.Le fait de cracher une variété de mucosités provenant des poumons nous donne une indication claire de l'existence ou non d'un problème au niveau des poumons.
par exempleLes personnes en bonne santé ont rarement des mucositéset sont également capables de bien contrôler leur comportement en matière de crachats. Par conséquent, le fait qu'une personne en bonne santé crache est un signe de manque d'étiquette.
Pharyngolaryngite aiguë ou chronique, cancer du larynx, stades précoces de la bronchite aiguë, compression trachéale, corps étrangers bronchiques, tumeurs bronchiques, maladie pleurale, hypertension pulmonaire primaire et sténose mitrale. La tendance est de tousser plus et d'expectorer moins.
但Les patients atteints de bronchite chronique, d'emphysème obstructif chronique, de bronchectasie avec infection, d'abcès pulmonaire, de fistule bronchopleurale et de carcinome alvéolaire ont généralement des expectorations plus abondantes.Je le sais très bien. À cet égard, j'ai une profonde compréhension du vieux père dans le passé, quand il était vivant, une fois les changements de saison, la bronchite chronique attaque, souvent le lendemain matin pour voir le crachoir de chevet de mon père dans une grande quantité de pus et de crachats, qui est encore petit, regarder le cœur du cœur est tellement effrayé. Cependant, selon la littérature, la maladie qui produit le plus d'expectorations est le carcinome alvéolaire, le volume des expectorations pouvant atteindre des centaines, voire des milliers de millilitres d'expectorations de mousse de plasma par jour.
Les infections bactériennes purulentes des voies respiratoires inférieures se caractérisent par l'expectoration d'une grande quantité de crachats purulents.Par exemple, la pneumonie, la bronchodilatation et l'infection, la bronchite chronique et l'infection, l'abcès pulmonaire, la tuberculose, etc., et les patients présentent souvent une combinaison de toux plus sévère et de différents degrés de fièvre, comme les manifestations de la tuberculose de faible fièvre, de toux et d'expectorations, de sueurs nocturnes.La couleur des expectorations varie selon les infections bactériennes.Cela permet de diagnostiquer la maladie.
- Si les expectorations sont de couleur rouille, il est confirmé que le patient souffre d'une pneumonie à pneumocoques.
- Des expectorations de couleur jaune-vert ou vert émeraude suggèrent une infection à Pseudomonas aeruginosa.
- Des crachats dorés suggèrent une infection à Staphylococcus aureus.
- Des crachats malodorants suggèrent une infection anaérobie.
Si le patient est alité depuis longtemps et qu'il tousseSi les expectorations sont blanches, épaisses et tirées, il faut envisager une infection fongique.Un échantillon doit être prélevé pour confirmer le diagnostic.
Crachats sanglants dus à l'agression des muqueuses des voies respiratoires, à des lésions des capillaires ou à des fuites de sang dans les alvéoles... Parmi les maladies les plus courantes, citons le cancer broncho-pulmonaire, la tuberculose et les lésions pulmonaires.
Si le patientEnvisager un œdème pulmonaire aigu en cas d'expectoration de grandes quantités de crachats roses et mousseux et de dyspnée.À ce moment-là, le patient est souvent accompagné d'agitation, de cyanose et de transpiration. À ce moment-là, le patient est souvent accompagné d'agitation, de cyanose, de sueurs abondantes, d'une accélération du rythme cardiaque, les deux poumons sont couverts de rhonchies et de râles humides et d'autres manifestations, et il convient d'administrer un traitement de secours en temps utile.
Et juste pour que vous le sachiez.L'expectoration de mucosités est un réflexe défensif normal du corps humain, une manifestation normale de l'élimination des substances nocives des poumons. Si vous avez des mucosités, vous devez les cracher autant que possible, afin de faciliter la guérison de la maladie.Si vous retenez les mucosités et que vous ne les expectoriez pas, cela aggravera souvent votre état et, dans les cas graves, cela peut même mettre votre vie en danger parce que les mucosités bloquent les voies respiratoires, entraînant une suffocation. En outre, les mucosités étant une substance nocive, elles peuvent égalementNe pas préconiser un comportement d'avalement des expectorationsCela expose les expectorations à un risque d'infection bactérienne du tube digestif, plus fréquemment observée chez certains patients atteints de tuberculose du tube digestif, souvent formée par l'ingestion d'expectorations contenant des bacilles tuberculeux provenant de la tuberculose pulmonaire.
Le flegme, la première chose qui vous donne l'impression d'être dégoûtant et sale !

En fait, le flegme est la sécrétion des bronches et des alvéoles des voies respiratoires inférieures, cette sécrétion est en grande partie une réponse à la protection de l'organisme. Lorsque les voies respiratoires humaines sont stimulées par des allergènes, la sécrétion respiratoire de mucus est stimulée en conséquence ; ce mucus est le principal composant des mucosités. Lorsque l'air contient un grand nombre d'impuretés, de poussières, de gaz froids, les poils du nez ne cessent de se balancer, ce qui stimule l'éternuement du nez. C'est la raison pour laquelle il y a des crottes de nez dans les narines !
Ces excrétions sont-elles donc nocives ?

Je peux vous dire très franchement que les expectorations humaines sont potentiellement dangereuses en toutes circonstances, de sorte que la prochaine génération devrait réglementer son comportement et ses paroles dans les lieux publics et ne pas cracher. La tuberculose est causée par Mycobacterium tuberculosis, une maladie infectieuse chronique qui peut envahir de nombreux organes, l'infection pulmonaire étant la plus courante. Mycobacterium tuberculosis peut être dispersé dans l'air par les expectorations, si les patients atteints de tuberculose ne sont pas civilisés, les crachats sont très dangereux, en plus de nombreuses infections virales respiratoires de la pneumonie peuvent être transmises par des gouttelettes, de sorte que dans les périodes spéciales hors de la meilleure ou consciemment porter un masque.
Qu'y a-t-il de mal à ce que du sang soit présent dans les expectorations ?

En ce qui concerne le problème du sang dans les expectorations, je me souviens qu'il y a quelques jours, lorsqu'un patient est venu faire un examen des expectorations, il a trouvé ses expectorations légèrement sanguines, il était très inquiet, se demandant s'il n'avait pas un cancer du poumon et ainsi de suite, mais heureusement nous avons fait un examen microscopique et une culture microbiologique des expectorations en même temps et il n'y avait pas de problème grave. L'air était trop sec depuis le début de l'hiver, ce qui a provoqué la rupture des capillaires des tubes respiratoires, et une trace de sang est apparue, mais son esprit de recherche des problèmes et sa volonté de se rendre activement à l'hôpital pour des examens de contrôle sont toujours bons.
En outre, les infections pulmonaires ou la bronchite, voire la bronchodilatation, les tumeurs malignes, la toux sévère, l'embolie pulmonaire, la tuberculose et d'autres maladies peuvent saigner et provoquer la présence de sang dans les expectorations. Ne soyez donc pas négligent lorsque cela se produit !
Je suis "Dr Yang said", je me concentre sur les sciences de la santé, comme si cela pouvait attirer l'attention ! Je vous remercie !
Lorsqu'il y a davantage de sécrétions ou de corps étrangers dans les voies respiratoires, ils sont expectorés ou avalés dans l'estomac grâce au réflexe de la toux, et cette réaction permet de maintenir les voies respiratoires ouvertes. La toux est donc un réflexe d'autodéfense et d'autoprotection.

La toux aide les voies respiratoires à expulser les corps étrangers qui les envahissent et les sécrétions excessives qu'elles produisent elles-mêmes, et elle a un effet nettoyant sur les voies respiratoires. Mais d'où viennent les mucosités ?
Les voies respiratoires sécrètent normalement du mucus pour rester humides, mais si une infection bactérienne se produit dans la trachée, les bronches ou les poumons, le mucus est de plus en plus abondant et finit par former des mucosités. C'est pourquoi les antitussifs puissants ne doivent pas être utilisés immédiatement lorsqu'une trop grande quantité de mucosités est expectorée.
Lorsque les expectorations sont plus abondantes, cela signifie que l'inflammation de la trachée, des bronches et des poumons se développe et qu'elle ne s'améliore pas tant que les expectorations ne diminuent pas lentement. Lorsque la couleur des expectorations est différente, l'état de santé est différent. En fonction de la couleur des expectorations, un plan de traitement différent doit être mis en place.
- Crachats blanc-gris, le plus souvent au début d'une infection des voies respiratoires supérieures.
- Crachats blancs et mousseux. Se rencontre le plus souvent dans les cas de bronchite ou d'asthme bronchique.
- Les expectorations purulentes jaune-vert indiquent une infection des poumons et sont généralement observées dans les abcès pulmonaires, les bronchectasies et les cas graves de tuberculose.
- Les expectorations sanglantes sont généralement dues à la tuberculose, au cancer broncho-pulmonaire, etc.
- Des expectorations roses et mousseuses sont le signe d'un emphysème.
- Les expectorations de couleur rouille sont généralement dues à une pneumonie lobaire causée par une infection à Streptococcus pneumoniae.
- Crachats noirs. Elles doivent être dues à la silice de charbon. Si une personne normale crache occasionnellement très peu de crachats noirs, cela doit être dû à l'inhalation d'une grande quantité de poussière dans l'air.

Une inflammation des poumons, des bronches, du rhinopharynx ou un temps sec peuvent provoquer la présence de sang dans les expectorations, mais s'il s'agit de sang occasionnel dans les expectorations une ou deux fois, il n'est pas possible de savoir immédiatement quelle est la cause exacte de la maladie.
Si la toux est légère, tant que les mucosités sont expectorées, il n'est pas nécessaire de se précipiter pour prendre un médicament contre la toux. Si les mucosités sont trop épaisses, vous pouvez boire davantage d'eau pour humidifier les voies respiratoires et fluidifier les mucosités, afin qu'elles soient plus faciles à expectorer.
Beaucoup de personnes qui crachent beaucoup de mucosités sont des fumeurs. L'arrêt du tabac peut donc avoir pour effet de prévenir l'inflammation des bronches. Vous pouvez également faire davantage d'exercices respiratoires pour entretenir vos poumons. Par exemple, des exercices d'expansion thoracique, des exercices de soufflage de bouteille.
Les poumons sont un organe délicat en médecine chinoise et craignent particulièrement la sécheresse. C'est pourquoi l'automne, saison sèche, devrait être propice à l'entretien des poumons. Les poumons sont des organes très importants pour le corps humain, car ils transportent l'oxygène et assurent les échanges gazeux. Il est donc très important de prendre soin des poumons au quotidien.

- Renforcer l'exercice physique pour améliorer la capacité pulmonaire. Une participation appropriée à l'exercice physique ou au travail peut améliorer la capacité pulmonaire. L'amélioration de la respiration peut favoriser les échanges gazeux entre les alvéoles et le sang, ce qui joue un rôle très important dans la santé pulmonaire et physique.
- Prévenir les infections bronchiques en ne fumant pas. Le tabagisme de première et de seconde main affecte le mouvement des cils respiratoires, de sorte que les corps étrangers et les bactéries présents dans les voies respiratoires ne peuvent pas être évacués correctement, ce qui, avec le temps, provoquera une inflammation, comme l'apparition et le développement de la bronchite chronique, qui est inextricablement liée au tabagisme.
C'est une bonne question ! Tout le monde a déjà craché des mucosités dans sa vie, mais peu de gens se demandent ce qui est craché par les poumons. S'agit-il de toxines ? Discutons-en aujourd'hui.
1) Comment les mucosités sont-elles produites ?
Tout d'abord, soyons clairs : l'expectoration de mucosités est une action d'autoprotection de notre corps pour dégager les voies respiratoires et expulser les corps étrangers, une aptitude à la survie développée au cours de l'évolution humaine. Comment les mucosités sont-elles produites ?
Nos voies respiratoires sont reliées au monde extérieur et, par le biais d'une expiration et d'une inspiration ininterrompues, le dioxyde de carbone est expulsé et l'oxygène est inhalé. Les virus, les bactéries ou les substances nocives contenues dans l'air envahissent les voies respiratoires lors de la respiration, après quoi les cellules en forme de coupelle de la paroi interne de la trachée enveloppent les substances nocives, qui sont ensuite évacuées du corps sous l'action des cils épithéliaux de la trachée. Les tissus ciliés de l'épithélium bronchique agissent comme une brosse, balayant les matières étrangères qui pénètrent dans la trachée lors de la respiration et les empêchant de descendre vers les alvéoles pour provoquer des maladies, ce que l'on appelle la fonction d'auto-épuration des voies respiratoires. Dans ces conditions normales de fonctionnement, il n'y a pas de production de mucosités. L'image ci-dessous illustre le fonctionnement normal des cils bronchiques. Elle est tirée de "How Pneumonia Forms" (Comment se forme la pneumonie) écrit par Mosquito Knowledge.

Cependant, sous l'action de diverses causes pathogènes, l'intrus externe est trop important et trop fort par rapport à la capacité d'auto-épuration des voies respiratoires, une inflammation se produit alors et des mucosités sont produites. L'inflammation se produit, le système immunitaire du corps se met en marche, les instructions des cellules immunitaires sécrètent des médiateurs inflammatoires pour tuer les "ennemis" étrangers, la muqueuse bronchique stresse également la sécrétion d'une grande quantité de mucus, la composition du fluide respiratoire change, la formation de mucosités se produit. Les mucosités stimulent le centre de la toux, produisent une toux et expulsent les mucosités de l'organisme, ce qui contribue à soulager la maladie.
2) Qu'est-ce que le flegme ? S'agit-il d'une toxine dans l'organisme ?
La composition des expectorations comporte deux aspects principaux : d'une part, les corps étrangers, les micro-organismes pathogènes, etc. ; d'autre part, l'épithélium bronchique qui sécrète du mucus, des cellules inflammatoires et des cellules épithéliales nécrosées, ainsi que d'autres composants.
D'après cette analyse de la composition, les mucosités ne sont pas considérées comme des toxines dans l'organisme, mais elles contiennent des substances étrangères, des micro-organismes pathogènes et d'autres substances nocives qui doivent être expulsées de l'organisme, de sorte que la thérapie par expectoration est une mesure importante dans le traitement clinique de l'inflammation des voies respiratoires.

3) Quelles sont les maladies respiratoires courantes qui entraînent l'expectoration ?
- Bronchite chronique : toux récurrente, expectorations et essoufflement, pendant une longue période, chaque crise durant plus de trois mois, pouvant se compliquer d'emphysème et de cardiopathie pulmonaire.
- Pneumonie : la pneumonie causée par divers agents pathogènes se manifeste presque toujours par des expectorations ; les infections à Streptococcus pneumoniae se traduisent par des expectorations rouillées, les infections bactériennes purulentes par des expectorations de pus, les expectorations amibiennes par des expectorations de couleur chocolat, Pseudomonas aeruginosa par des expectorations teintées de pus et par des expectorations vertes ou vert jaunâtre.
- Tuberculose : Toux avec expectoration de sang, pouvant être accompagnée de fièvre, de sueurs nocturnes et d'une augmentation de l'expectoration en cas de formation d'une cavité pulmonaire.
- Dilatation des bronches : toux avec expectoration de beaucoup de pus, après repos, l'expectoration peut être divisée en trois couches : la couche supérieure est constituée de mucus mousseux, la couche intermédiaire est constituée de plasma visqueux, la couche inférieure est constituée de pus extra visqueux et de tissus nécrotiques.
- Abcès pulmonaire : expectoration d'une grande quantité de crachats purulents, pouvant atteindre 300 à 500 ml par jour.
- Cancer du poumon : Toux avec expectorations fines ou épaisses, parfois avec du sang.

4) Quelles sont les méthodes courantes d'expectoration ?
Les méthodes expectorantes visent à diluer les mucosités et à favoriser leur expectoration afin de soulager les symptômes. Méthodes couramment utilisées.
Boire beaucoup d'eau : cela peut aider à diluer les mucosités et à faciliter l'évacuation des mucosités par la toux.
Utilisez un humidificateur pour augmenter l'humidité de l'air et faciliter l'expectoration des mucosités.
Utilisation d'expectorants : chlorure d'ammonium, ambroxol, N-acétylcystéine, herbes chinoises, etc.
La composition des expectorations comprend principalement des corps étrangers, des micro-organismes pathogènes, des mucosités sécrétées par l'épithélium bronchique, des cellules inflammatoires et des cellules épithéliales nécrosées, ainsi que d'autres composants contenant des substances nocives, mais qui ne sont pas considérées comme des toxines, et qui doivent être évacuées de l'organisme. Les maladies courantes liées à la toux sont principalement les maladies infectieuses respiratoires, la dilatation des bronches, le cancer du poumon, etc. Les principales mesures expectorantes consistent à diluer les expectorations pour faciliter la toux.
(Contribution du Dr Jia, Institut des maladies infectieuses, deuxième hôpital de l'université médicale de Tianjin)
L'expectoration de mucosités est un phénomène très courant dans notre vie, parfois physiologique, parfois pathologique. Les patients s'interrogent souvent : "D'où viennent les mucosités ? "La morve se transforme-t-elle en mucosités lorsqu'elle n'est pas évacuée ? "Les crachats fréquents aident-ils le corps à se désintoxiquer ? etc. En réponse à ces questions, voici une vulgarisation des connaissances sur les mucosités.

Production de mucosités
La paroi de la trachée et des bronches est recouverte d'une membrane muqueuse, qui comporte de nombreuses glandes muqueuses et plasmatiques dans la couche sous-muqueuse et s'ouvre à la surface de la membrane muqueuse. Dans des circonstances normales, les cellules et les glandes sécrètent une petite quantité de mucus pour recouvrir les parois de la trachée, qui sert à protéger, lubrifier et adhérer aux substances nocives. Lorsque la trachée est attaquée par des substances nocives, ou en cas d'irritation ou d'infection par des germes, les glandes de la trachée augmentent leur sécrétion et le mucus augmente, ce qui constitue le mécanisme d'autoprotection de l'organisme pour expulser les substances étrangères. Lorsque nous crachons ce mucus avec des tissus nécrosés et des agents pathogènes, il s'agit de mucosités. Certains patients souffrant de rhinite peuvent également présenter une augmentation des mucosités, car lorsque l'infection se situe à l'arrière des voies nasales, l'excès de morve remonte dans la gorge, mais il ne s'agit pas de mucosités sécrétées par la trachée, et les mucosités ne sont donc pas identiques à la morve.
Flegme et "toxines
Tout d'abord, il est important de préciser ce que l'on entend par "toxines". Lorsque l'on crache, les expectorations contiennent généralement des irritants tels que de la poussière, des particules de poussière, etc., ou des agents pathogènes tels que des bactéries, des virus, etc. Ces substances sont en effet des "toxines" pour l'organisme et doivent être éliminées. Cependant, certains patients pensent qu'ils peuvent augmenter la quantité de mucosités qu'ils produisent quotidiennement en expulsant des mucosités ou en prenant certains compléments alimentaires afin de se débarrasser des "toxines des cinq organes et des six intestins", ce qui est un point de vue qui n'est pas étayé. Une augmentation soudaine de la quantité de mucosités, une grande quantité de mucus, des mucosités jaune-vert et d'autres phénomènes ne peuvent pas simplement être considérés comme une désintoxication, plus il y en a, mieux c'est, mais il faut y prêter attention en tant que signaux de danger pour la santé qui nous incitent à consulter un médecin pour trouver l'origine de la maladie.
En cas de production accrue d'expectorations, s'il y a également une augmentation de la morve nasale et des crottes de nez, un écoulement nasal facile contre le vent et une sensation de mucus s'écoulant de l'arrière du nez dans la gorge, il est généralement nécessaire d'exclure la possibilité d'une rhinite, d'une sinusite et d'autres maladies.
Lorsque l'on est sûr que l'augmentation des expectorations est due à des problèmes respiratoires, on peut observer le caractère et la couleur des expectorations pour aider au diagnostic de la maladie. Par exemple, des expectorations de pus jaune et vert : suggèrent une infection bactérienne des poumons, une pneumonie, une bronchite, etc. ; des expectorations de couleur rouille : suggèrent une pneumonie lobaire, une obstruction pulmonaire, etc. ; des expectorations de couleur chocolat : suggèrent une maladie pulmonaire amibienne, etc. ; des expectorations mousseuses roses : suggèrent une insuffisance cardiaque, un œdème pulmonaire, une maladie cardiaque pulmonaire, etc. ; des expectorations rouge vif : suggèrent un traumatisme, une tuberculose, une obstruction pulmonaire, un cancer du poumon, etc. ; des expectorations brunes : suggèrent un envasement des expectorations en cas de maladie cardiaque chronique, etc.
Les cliniciens encouragent généralement les patients à essayer de ne pas avaler leurs expectorations, afin d'éviter que les agents pathogènes ne provoquent des infections secondaires gastro-intestinales. Les patients qui n'ont pas la capacité d'expulser eux-mêmes leurs expectorations peuvent choisir d'être aidés par des médicaments chimiothérapeutiques et des opérations d'aspiration des expectorations. Les expectorations contiennent généralement des substances nocives, et nous devons donc les expulser de l'organisme autant que possible afin d'atteindre l'objectif d'élimination des "toxines".
Ces questions et réponses proviennent des utilisateurs du site, elles ne représentent pas la position du site, s'il y a une infraction, veuillez contacter l'administrateur pour la supprimer.